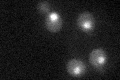
YDR073W
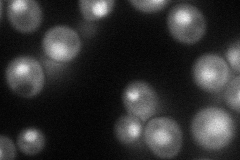
YDR073W
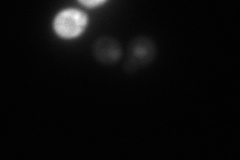
YDR073W
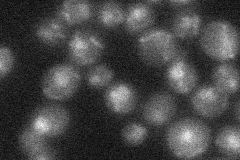
YDR073W
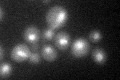
YDR073W
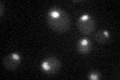
YDR073W

View description
Subunit of the SWI/SNF chromatin remodeling complex involved in transcriptional regulation; interacts with a highly conserved 40-residue sequence of Snf2p
Localization:
Intensity:
Fold change:
Significance:
-
C’ GFP library in SD
nucleus27.14 -
N' NOP1pr-GFP in SD
nucleus53.3911 -
N' TEF2pr-mCherry in SD
nucleus47.9176 -
N' NATIVEpr-GFP in SD
nucleus24.8182 -
N' TEF2pr-VC and Cyto-VN in SD

#N/A0 -
C’ GFP library in SD+DTT
nucleus20.030.73Yes -
C’ GFP library in SD+H2O2

nucleus22.820.84No -
C’ GFP library in Starvation Media
nucleus23.440.86No -
C’ GFP library on the background of Pup2-DaMP

nucleus -
C’ GFP library on the background of CCT mutant

nucleus25.97530.956995No
